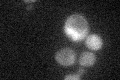
YOL143C
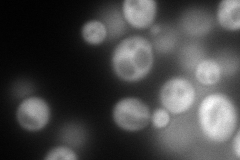
YOL143C
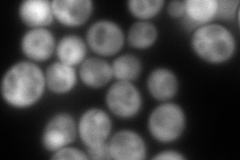
YOL143C
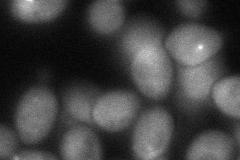
YOL143C
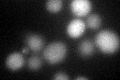
YOL143C

View description
Lumazine synthase (6,7-dimethyl-8-ribityllumazine synthase, also known as DMRL synthase); catalyzes synthesis of immediate precursor to riboflavin
Localization:
Intensity:
Fold change:
Significance:
-
C’ GFP library in SD
cytosol23.44 -
N' NOP1pr-GFP in SD
cytosol290.418 -
N' TEF2pr-mCherry in SD
cytosol403.21 -
N' NATIVEpr-GFP in SD

cytosol40.7162 -
N' TEF2pr-VC and Cyto-VN in SD
cytosol66.0091 -
C’ GFP library in SD+DTT
cytosol31.311.33Yes -
C’ GFP library in SD+H2O2

cytosol20.710.88No -
C’ GFP library in Starvation Media

cytosol60.122.56Yes -
C’ GFP library on the background of Pup2-DaMP

cytosol -
C’ GFP library on the background of CCT mutant

cytosol22.26690.949601No
